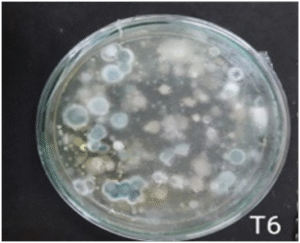

जैविक खेती में वर्ष 2015-16 से 2021-22 के दौरान विकसित नई तकनीकें
ICAR- All India Network Project on Organic Farming
1. Durum Wheat / काठा गेहूं
- Durum wheat variety HI-8713 for high yield under organic production system for southern Rajasthan.
- दक्षिणी राजस्थान के लिए जैविक उत्पादन प्रणाली के तहत उच्च उपज हेतु काठा गेहूं की किस्म HI-8713 का प्रयोग करें ।
2. Sweet Corn / मीठी मक्का
- Technology for organic sweet corn production.
(1/3 of RDN by NADEP compost + 1/3 by vermicompost + 1/3 by Non-edible cake + BF) + Innovative practices (BD 500 @ 75g/ha before sowing & 30 DAS + BD 501 @ 2.5g/ha @ 2-4 leaf stage + Mataka Khad 10% at 3 WAS + Panchagavya @ 3% 6 WASfor higher yield of sweet corn.) - जैविक मीठी मक्का उत्पादन तकनीक हेतु 75 प्रतिशतजैविक (1/3 आरडीएन नाडेप कम्पोस्ट + 1/3 वर्मीकम्पोस्ट + 1/3 नहीं खाने योग्य खलियों + जैव उर्वरक) + नवाचार प्रक्रियाऐं (बुवाई पूर्व एवं बुवाई के 30 दिन बाद बीडी 500 का 75 प्रतिशत प्रति हैक्टेयर की दर से + 2 से 4 पत्ती अवस्था पर बीडी 501 का 2.5 ग्राम प्रति हैक्टेयर की दर से + बुवाई के तीन सप्ताह बाद 10 प्रतिशतमटका खाद + बुवाई के छः सप्ताह बाद 3 प्रतिशत पंचगव्य) का प्रयोग करें।
3. Wheat / गेहूं
- Organic farming practices for high yield of wheat (variety Raj-4037 and HI-8663)
- जैविक खेती प्रक्रियाओं के तहत गेहूं की अधिक उपज के लिए चपाती गेहूं की किस्म Raj-4037 एवं काठा गेहूं की किस्म HI-8663 का प्रयोग करें ।
4. Fenugreek / मैथी
- Organic farming practices for high yield of fenugreek (variety RMT-305)
- जैविक खेती में मैथी (किस्म RMT-305) के अधिक उत्पादन हेतु 75 प्रतिशतजैविक (1/3 आरडीएन नाडेप कम्पोस्ट + 1/3 वर्मीकम्पोस्ट + 1/3 नहीं खाने योग्य खलियों + जैव उर्वरक) + नवाचार प्रक्रियाऐं (बुवाई पूर्व एवं बुवाई के 30 दिन बाद बीडी 500 का 75 प्रतिशत प्रति हैक्टेयर की दर से + 2 से 4 पत्ती अवस्था पर बीडी 501 का 2.5 ग्राम प्रति हैक्टेयर की दर से $ बुवाई के तीन सप्ताह बाद 10 प्रतिशत मटका खाद + बुवाई के छः सप्ताह बाद 3 प्रतिशत पंचगव्य) का प्रयोग करें।
5. Gram / चना
- Organic farming practices for high yield of gram (variety GNG-1581)
- जैविक खेती में चने (किस्म GNG-1581) के अधिक उत्पादन हेतु 75 प्रतिशत जैविक (1/3 आरडीएन नाडेप कम्पोस्ट + 1/3 वर्मीकम्पोस्ट + 1/3 नहीं खाने योग्य खलियों + जैव उर्वरक) + नचाचार प्रक्रियाऐं (बुवाई पूर्व एवं बुवाई के 30 दिन बाद बीडी 500 का 75 प्रतिशत प्रति हैक्टेयर की दर से + 2 से 4 पत्ती अवस्था पर बीडी 501 का 2.5 ग्राम प्रति हैक्टेयर की दर से + बुवाई के तीन सप्ताह बाद 10 प्रतिशतमटका खाद + बुवाई के छः सप्ताह बाद 3 प्रतिशत पंचगव्य) का प्रयोग करें।
6. Sweet Corn / मीठी मक्का
- Sweet corn variety Sugar-75 for high yield under organic production system for Southern Rajasthan.
- दक्षिणी राजस्थान के लिए जैविक उत्पादन प्रणाली के तहत उच्च उपज हेतु मीठी मक्का की किस्म Sugar-75 का प्रयोग करें ।
7. Maize, Sweet Corn, Blackgram & Soybean / मक्का, मीठी मक्का, उड़द एवं सोयाबीन
- Application of (1/3 of RDN by NADEP compost+ 1/3 by vermicompost +1/3 by Non-edible cake +BF)+ (BD+500 @75g/ha before sowing & 30 DAS+ BD 501 @2.5 g/ha @2-4 leaf stage + Mataka Khad 10% at 3 WAS+ Panchagavya @3% 6 WAS for organic production of maize, sweet corn, blackgram and soybean.
- मक्का, मीठी मक्का, उड़द एवं सोयाबीन के जैविक उत्पादन के लिए 75 प्रतिशत जैविक (1/3 आरडीएन नाडेप कम्पोस्ट + 1/3 वर्मीकम्पोस्ट + 1/3 नहीं खाने योग्य खलियों + जैव उर्वरक) + नवाचार प्रक्रियाऐं (बुवाई पूर्व एवं बुवाई के 30 दिन बाद बीडी 500 का 75 प्रतिशत प्रति हैक्टेयर की दर से + 2 से 4 पत्ती अवस्था पर बीडी 501 का 2.5 ग्राम प्रति हैक्टेयर की दर से + बुवाई के तीन सप्ताह बाद 10 प्रतिशत मटका खाद + बुवाई के छः सप्ताह बाद 3 प्रतिशत पंचगव्य) का प्रयोग करें।
8. Maize/ मक्का
- Variety Pratap Hybrid Maize-3 for higher yield under organic farming
- जैविक खेती के तहत उच्च उपज हेतु मक्का की किस्म PHM-3 का प्रयोग करें ।
9. Integrated Organic Farming / जैविक खेती प्रणाली का एक मॉडल
- An Integrated Organic Farming system for 0.45 ha consisting of field crops in 0.25 ha (sweet corn + blackgram during kharif and wheat during rabi), fodder crops in 0.05 ha. (fodder maize + fodder cowpea during kharif and berseem in rabi and sesbania etc. green manuring during zaid, vegetables in 0.10 ha (cluster bean, coriander & okra etc) fruit crop in 0.04 ha (guava) and compost unit in 0.01 ha for sub-humid agro climatic zone of Rajasthan.
- राजस्थान के उप आर्द्ध सस्य जलवायु क्षेत्र में 0. 45 हैक्टेयर में जैविक खेती प्रणाली का एक मॉडल विकसित किया गया हैए जिसके अन्तर्गत 0.25 हैक्टेयर क्षेत्र में सस्य फसलों में खरीफ के दौरान मीठी मक्का (स्वीट कॉर्न), उड़द (2:2) तथा रबी में गेहूं, 0.05 हैक्टेयर में चारा फसलों में खरीफ के दौरान मक्का + चंवला की चारा वाली किस्में तथा रबी में बरसीम और जायद में हरी खाद के लिए ढ़ेंचा, 0.10 हैक्टेयर में सब्जियों में ग्वार, धनियाँ तथा भिण्डी, 0.04 हैक्टेयर में फल वाली फसलों में अमरूद एवं 0.01 हैक्टेयर में खाद की इकाई तैयार करें।
10. Fenugreek, Fennel & Coriander / मेथी, सौंफ एवं धनिया
- Application of 1/3 of recommended dose of nitrogen (RND) through FYM + 1/3 of RND through vermicompost +1/3 RDN through oilcakes + Jeevamrit@500 litre/ha at 1st and 3rd irrigation + BD 500 (At sowing & 30 DAS) + BD 501 at 2-4 stage + At flowering stage for higher yield of fenugreek, fennel and coriander under organic farming.
- जैविक पोषक तत्व प्रबंधन द्वारा मेथी, सौंफ एवं धनिया के अधिक उत्पादन के लिए नाइट्रोजन की सिफारिश मात्रा का एक तिहाई भाग गोबर की खाद, एक तिहाई भाग केंचुआ खाद, एक तिहाई भाग नीम की खली द्वारा जीवामृत 500 लीटर/है की दर से पहली एवं तीसरी सिचाई पर- जैव गतिको नुस्खा 500 (75 ग्राम 40 लीटर पानी में) का बुवाई पर एवं बुवाई के 30 दिन के बाद तथा जैव गतिकी नुस्खा 501 (2.5 ग्राम 40 लीटर पानी में) का 2-4 पत्ती की अवस्था पर एवं फूल बनने की अवस्था पर उपयोग करें।
11. Weed Management – Fennel / खरपतवार प्रबंधन – सौंफ
- Stale Seed Bed technique + plastic mulch (25 micron) at sowing for effective organic weed management in fennel
- सौंफ में प्रभावी जैविक खरपतवार प्रबंधन के लिए बुवाई के समय बीज शय्या तकनीक + प्लास्टिक मल्च (25 माइक्रोन) का प्रयोग करें ।
12. Weed Management – Sweet Corn / खरपतवार प्रबंधन – मीठी मक्का
- Stale Seed Bed technique + plastic mulch (25 micron) at sowing for effective organic weed management in sweet corn
- मीठी मक्का में प्रभावी जैविक खरपतवार प्रबंधन के लिए बुवाई के समय बीज शय्या तकनीक + प्लास्टिक मल्च (25 माइक्रोन) का प्रयोग करें ।
13. Weed Management – Soybean / खरपतवार प्रबंधन – सोयाबीन
- Weed management by application of stale seed bed by giving pre sowing irrigation + reduced spacing by 25% i.e. 22.5 cm row to row spacing + after sowing mulching with crop residues @ 5 t/ha + one hand weeding at 20 DAS for high yield of soybean under organic production system.
- जैविक खेती प्रणाली के तहत सोयाबीन में अधिक उपज हेतु खरपतवार प्रबंधन के लिए बीज शय्या तकनीक + पंक्ति से पंक्ति के बीच का अन्तराल 25 प्रतिशत कम करके (पंक्ति से पंक्ति के बीच का अन्तराल 22.5 सेमी) + बुवाई के बाद फसल अवशेष 5 टन/हे की दर से पलवार + बुवाई के 20 दिन के बाद एक बार हाथ से निराई करें ।
ICAR- All India Network Project on Organic Farming
14. Jeevamrut, Vermiwash, Panchagavya, Compost Tea, BD 500 & BD 501
- Methods of preparation and use of Jeevamrut, Vermiwash, Panchagavya, Compost Tea, BD 500 & BD 501 for use in organic production system.
- जैविक खेती प्रणाली में काम लेने के लिए जीवामृत, वर्मीवाश, पंचगव्य, खाद की चाय, जैव गतिकी नुस्खा 500 एवं 501 के तैयार करने की विधियाँ
15. Ecofriendly Nutrient and Disease Management/ पर्यावरण हितैषी पोषक तत्व और रोग प्रबंधन
- Protocol of preparation and characteristics of Vermiwash, Vermicompost, Enriched compost, Mataka Khad, Jeevamruta, Teekha sat and Cow urine based biostimulants (CUBS)
- वर्मीवाश, वर्मीकम्पोस्ट, संवर्धित खाद, मटका खाद, जीवामृत, तीखा सत एवं CUBS को तैयार करने का प्रोटोकोल एवं विशेषताओं का विश्लेषण
16. Jeevamrut for Wheat/ गेहूं के लिए जीवामृत
- Foliar application of jeevamrut@10% at 75 and 95 DAS in for higher yield wheat under organic farming
- जैविक खेती में गेहूं की अधिक उपज के लिए 10% जीवामृत का बुवाई के 75 एवं 90 दिन के बाद पर्णीय छिडकाव करें
17. Jeevamrut – Maize / जीवामृत – मक्का
- Application of 200 lit. Jeevamrit incubated with 1 kg Rock Phosphate (0.5%) + 1 kg Gypsum (0.5%) + 0.5 kg Silica (0.25%) at knee height and silking stage in organic maize
- जैविक मक्का में अधिक उत्पादन के लिए 200 लीटर जीवामृत को 1 किग्रा रॉक फोस्फेट+ 1 किग्रा जिप्सम + 500 ग्राम सिलिका से संवर्धित करके घुटने एवं मादा मंजरी अवस्था पर प्रयोग करें
18. Panchgavya – Maize/ पंचगव्य – मक्का
- Application of Panchgavya incubated for 30 days with rock phosphate 500g+ Silica 500g+ Mica 500g (Super Panchagavya) at knee hight and silking stage in organic maize
- जैविक मक्का में अधिक उत्पादन के लिए पंचगव्य को 500 ग्राम रॉक फोस्फेट + 500 ग्राम सिलिका + 500 ग्राम मायका से 30 दिन तक संवर्धित करके घुटने एवं मादा मंजरी अवस्था पर प्रयोग करें
19. Dashparni – Maize/ दशपर्णी – मक्का
- Application of Dashparni (10%) spray at knee height and silking stage in organic maize
- जैविक मक्का में कीट प्रबंधन के लिए 10% दशपर्णी का घुटने एवं मादा मंजरी अवस्था पर छिडकाव करें
20. Teen Ghol Jaiv Keetnashi – Blackgram/ तीन घोल जैव कीटनाशी – उड़द
- Application of Teen Ghol Jaiv Keetnashi (10%) at 30 DAS & 15 days after first spray in organic blackgram
- जैविक उड़द में कीट प्रबंधन के लिए 10% तीन घोल जैव कीटनाशी का बुवाई के 30 दिन के बाद एवं प्रथम छिडकाव के 15 दिन बाद छिडकाव करें
21. Jeevamrit – Blackgram/ जीवामृत – उड़द
- Application of 2 lit Jeevamrit + 50ml Lemon leaf extract (2.5%) + 50ml Aloevera leaf extract (2.5%) + 100 ml Vermiwash (5%) + 20 gm Silica (1%) spray at 15 DAS & 10% flowering in organic blackgram
- जैविक उड़द में 2 लीटर जीवामृत + 50 मिली लेमन घांस का रस + 50 मिली ग्वारपाठा पत्ती रस + 100 मिली वर्मीवाश + 20 ग्राम सिलिका का बुवाई के 15 दिन बाद एवं 10 % फुल बनने की अवस्था पर छिडकाव करें
22. Vermiwash- Blackgram/ वर्मीवाश – उड़द
- Application of Vermiwash produced from 100% cowdung spray at 15 DAS & 10% flowering in organic blackgram
- जैविक उड़द में 100% गाय के गोबर से बने वर्मीवाश का बुवाई के 15 दिन बाद एवं 10 % फुल बनने की अवस्था पर छिडकाव करें
23. CUBS – Okra/ CUBS- भिन्डी
- Application of Cow Urine based Bio- stimulant (CUBS) spray @ 15 % at flowering & fruit formation stage in organic Okra
- जैविक भिन्डी में 15% CUBS का फुल बनने एवं फल बनने की अवस्था पर छिडकाव करें
24. Vermicompost/ वर्मीकम्पोस्ट
- Recommendations for time of preparation, height of piling material, different structures for preparation and maximum recovery percentage of vermicompost.
- वर्मीबेड की उचाई 1.5 फीट तक रखने पर सबसे कम समय में वर्मीकम्पोस्ट तैयार होता है तथा अधिक मात्रा में केंचुआ उत्पादन होता है | वर्मीकम्पोस्ट बनाने की विभिन सरंचनाओ के अंतर्गत सतही विधि (10 फीट लम्बा, 4 फीट चोडी तथा 1.5 फीट ऊँची बेड) द्वारा सबसे कम समय में ज्यादा मात्रा में उच्च गुणवत्ता का वर्मीकम्पोस्ट तैयार होता हैं
25. BD-500 – Okra/ बी डी-500 – भिन्डी

- Soil application of BD-500 @ 3g/lit after stirring it for 30 minutes for maximum germination of organic okra.
- जैविक भिन्डी में सर्वाधिक अंकुरण प्राप्त करने के लिए बी डी -500 के 3 ग्राम प्रति लीटर के घोल को 30 मिनट (घडी की दिशा एवं घडी की विपरीत दिशा में) तक अच्छी तरह से हिलाने के बाद बुवाई के समय मृदा में उपयोग करे
26. BD-500 – Soybean/ बी डी-500 – सोयाबीन

- Soil application of BD-500 @ 3g/lit after stirring it for 30 minutes for maximum germination of organic soybean.
- जैविक सोयाबीन में सर्वाधिक अंकुरण प्राप्त करने के लिए बी डी -500के 3 ग्राम प्रति लीटर के घोल को 30 मिनट (घडी की दिशा एवं घडी की विपरीत दिशा में) तक अच्छी तरह से हिलाने के बाद बुवाई के समय मृदा में उपयोग कर
27. BD-500 – Green Chilli/ बी डी-500 – मिर्ची

- Soil application of BD-500 @ 3g/lit after stirring it for 30 minutes for maximum germination of organic chilli.
- जैविक मिर्ची में सर्वाधिक अंकुरण प्राप्त करने के लिए बी डी -500के 3 ग्राम प्रति लीटर के घोल को 30 मिनट (घडी की दिशा एवं घडी की विपरीत दिशा में) तक अच्छी तरह से हिलाने के बाद बुवाई के समय मृदा में उपयोग करे
28. BD-501 – Okra/ बी डी-501 – भिन्डी

- Soil application of BD-501 @ 3g/lit after stirring it for 30 minutes for maximum germination of organic okra.
- जैविक भिन्डी में सर्वाधिक अंकुरण प्राप्त करने के लिए बी डी -501के 3 ग्राम प्रति लीटर के घोल को 30 मिनट (घडी की दिशा एवं घडी की विपरीत दिशा में) तक अच्छी तरह से हिलाने के बाद बुवाई के समय मृदा में उपयोग कर
29. BD-501 – Green Chilli/ बी डी-501 – मिर्ची

- Soil application of BD-501 @ 3g/lit after stirring it for 30 minutes for maximum germination of organic chilli.
- जैविक मिर्ची में सर्वाधिक अंकुरण प्राप्त करने के लिए बी डी -501के 3 ग्राम प्रति लीटर के घोल को 30 मिनट (घडी की दिशा एवं घडी की विपरीत दिशा में) तक अच्छी तरह से हिलाने के बाद बुवाई के समय मृदा में उपयोग करे
30. BD-501 – Soybean/ बी डी-501 – सोयाबीन

- Soil application of BD-501 @ 3g/lit after stirring it for 30 minutes for maximum germination of organic soybean.
- जैविक सोयाबीन में सर्वाधिक अंकुरण प्राप्त करने के लिए बी डी -501के 3 ग्राम प्रति लीटर के घोल को 30 मिनट (घडी की दिशा एवं घडी की विपरीत दिशा में) तक अच्छी तरह से हिलाने के बाद बुवाई के समय मृदा में उपयोग करे
31. Cauliflower/ फुल गोभी

- Application of 100 % recommended dose of nitrogen in cauliflower through splitting 1/3 of total dose of nitrogen through FYM, 1/3 through Phosphate Rich Organic Manure (PROM) and 1/3 through neem cake for higher yield of organic cauliflower.
- फुल गोभी की फसल की अधिकतमउपज के लिए नाइट्रोजन की सिफारिश की खुराक का 1/3 भाग FYM से + 1/3 भाग PROM + 1/3 भाग नीम की खल से एवं कर्ड बनते समय तथा कर्ड बनने के 15 दिन के बाद 3: पंचगव्य का छिडकाव करें
32. Dashparni, Teekhasat , CUBS / दशपर्णी, तीखा सत एवं गाय आधारित जैव उत्प्रेरक
![]()
- Protocol and biochemical characteristics of Dashparni, Teekhasat and Cow urine based biostimulants.
- दशपर्णी, तीखा सत एवं गाय आधारित जैव उत्प्रेरक का प्रोटोकोल एवं जैव रासायनिक विशेषताओं का विश्लेषण
33. Cow Dung with Trichoderma / ट्राइकोडर्मा + गाय का गोबर
- Soil application of 3 kg Trichoderma species (WP) formulation on 100 kg cowdung (5 to 7 days old) by mixing in three layers and incubate for 15 days for getting optimum CFU (more than ˃ 107 per gram of cow dung).
- 3 किलो ट्राइकोडर्मा स्पिसिज़ (डब्लू पी) को 100 किलो 7 दिन पुराने गाय के गोबर में तीन परतो में मिलाकर 15 दिन के लिए संवर्धित कर बुवाई से पूर्व भूमि उपचार करने से सर्वाधिक सूक्ष्मजीवों की संख्या पाई गयी ।
34. Protocol for preparation / प्रोटोकोल

- Protocol for preparation of Bhabhot Amrit Paani, Jeevamrit, Aerated Pachgavya, Aerated Jeevamrit, Aerated compost tea and Aerated matka khad and their characteristics.
- भभूत अमृत पानी, जीवामृत, वायवीय पंचगव्य, वायवीय जीवामृत, वायवीय खाद की चाय एवं वायवीय मटका खाद को बनाने का प्रोटोकोल
35. Storing Maize & Blackgram Seed / मक्का एवं उड़द के बीजों का भण्डारण

- Use of plastic containers & polythene bags of 700 gauge as storage bins for storing maize & blackgram seed.
- जैविक मक्का एवं उड़द के बीजों के भण्डारण हेतु प्लास्टिक के पात्र एवं 700 गेज वाली पॉलिथीन बैग का उपयोग करे।
36. Pest Management in Okra / भिन्डी में कीट प्रबंधन

- Application of seed treatment/seedling treatment with babhut amrit pani + foliar spray of desi ark (10 kg neem leaves + 5 kg neem seed kernel + 2 kg aak leaves + 2 kg datura leaves + 50 l water, all boiled & sieved & mixed in 200 l water & sprayed in one acre) at 30 & 45 DAS for pest management in okra under organic farming.
- जैविक खेती में भिन्डी में कीट प्रबंधन हेतु भभूत अमृत पानी से बीज/पोध उपचार + देशी अर्क (10 किग्रा नीम पत्ती + 5 किग्रा निम्बोली + 2 किग्रा आक की पत्ती + 2 किग्रा धतूरा पत्ती + 50 लीटर पानी को गर्म करके छाने एवं 200 लीटर पानी में मिला कर 1 एकड के लिए) का बुवाई के 30 एव 45 दिन के बाद पर्णीय छिडकाव करें
37. Sucking Pest Management in Okra / भिन्डी में रस चूसने वाले कीटों का नियंत्रण

- Application of 20% liquid mixture of Cow dung slurry + Cow urine (1:1) mixed with water and sprays twice at initiation of infestation and 10 days interval) for management of sucking pest management in okra.
- भिन्डी में रस चूसने वाले कीटों के नियंत्रण हेतु 20 प्रतिसत गोबर की स्लरी और गोमूत्र (1:1) को पानी में घोल बना कर कीट दिखाई देने पर एवं उसके 10 दिन बाद छिडकाव करें
38. Dashparni – Brinjal / दशपर्णी – बैंगन

- Application of Dashparni @ 10% at 30 & 45 DAS for organic management of brinjal shoot and fruit borer of brinjal
- जैविक खेती के अंतर्गत बैंगन में तना एवं फल छेदक कीट के प्रभावी नियंत्रण के लिए दशपर्णी के 10 प्रतिशत घोल का 2 बार छिडकाव (बुवाई के 30 तथा 45 दिन पर) करें
39. Dashparni – Bottle guard/ दशपर्णी – लोकी

- Application of Dashparni @ 10% at 30 & 45 DAS for organic management of Alternaria blight of bottle guard.
- जैविक खेती के अंतर्गत लोकी में अल्टरनेरिया ब्लाइट रोग के प्रभावी नियंत्रण के लिए दशपर्णी के 10 प्रतिशत घोल का 2 बार छिडकाव (बुवाई के 30 तथा 45 दिन पर) करें
40. Compost tea – Soybean/ सोयाबीन

- Application of compost tea @ 1250 l ha-1 as soil application with first irrigation and 100 % compost tea as foliar spray at 30 and 45 DAS for high yield and quality of soybean.
- जैविक खेती के अंतर्गत सोयाबीन की अधिक उपज एवं गुणवता के लिए 1250 लीटर/हे खाद की चाय पहली सिचाई के साथ मृदा में और बुवाई के 30 एवं 45 दिन बाद 100 प्रतिशत खाद की चाय का छिडकाव करें
41. PROM, BD-500, BD-501 – Blackgram/ उड़द

- Application of 100 per cent RDP through PROM manure at sowing + BD-500 (75 g ha-1 in 40 l water before sowing) + BD-501 (2.5 g ha-1 in 40 l water at 2-3 leaf stage) for better yield in blackgram under organic farming.
- जैविक खेत में उड़द की अधिक उपज हेतु पोस्फोरुस की सम्पूर्ण मात्रा प्रोम से बुवाई के समय डाले + बी डी -500 बुवाई के समय + बी डी -501 दो से तीन पतियों की अवस्था पर छिडकाव करें
42. Panchagavya- Blackgram/ पंचगव्य – उड़द

- Application of 3% aerated panchagavya at 30 & 45 DAS for higher yield and quality of blackgram under organic farming.
- जैविक खेती के अंतर्गत उड़द की अधिक उपज एवं गुणवता के लिए बुवाई के 30 एवं 45 दिन बाद 3 प्रतिसत पंचगव्य का छिडकाव करें
43. Enriched compost + Panchagavya+ Jeevamrit + Beejamrit – Sweet corn/ संवर्धित खाद + पंचगव्य + जीवामृत + बीजामृत – मक्का

- Application of enriched compost (6t/ha at sowing) + panchagavya (5% foliar spray at flowering stage and 15 days after flowering stage) + Jeevamrit (5% foliar spray at flowering stage and 15 days after flowering stage) + Beejamrit for seed treatment for higher yield of sweet corn under organic production system.
- जैविक मक्का की अधिक उपज के लिए बुवाई के समय 6 टन/हे संवर्धित खाद + फुल आते समय और उसके 15 दिन बाद 5 प्रतिसत पंचगव्य का छिडकाव + फुल आते समय और उसके 15 दिन बाद 5 प्रतिसत जीवामृत का छिडकाव + बीजामृत से बीज उपचार करना चाहिए
44. Cow dung + farm waste for Vermicompost preparation/ गुणवत्ता युक्त वर्मीकम्पोस्ट

- Use of cow dung and farm waste 50 kg (45 kg cow dung + 5 kg farm waste) with 5 kg earthworm for minimum time of vermicompost preparation & maximum recovery of vermicompost.
- 45 किग्रा गोबर + 5 किग्रा भूसा (कुल 50 किग्रा जैविक पदार्थ) के मिश्रण में 5 किग्रा केंचुए डालने से कम समय एवं अधिक मात्रा में गुणवत्ता युक्त वर्मीकम्पोस्ट तैयार होता है I
45. Vermicompost + Vermiwash + Panchgayva – Potato / वर्मीकम्पोस्ट+ वर्मीवाश + पंचगव्य – आलू
- Application of Vermicompost (8 t/ha) at sowing + vermiwash (10%) spray at 30 and 45 DAS + Panchagavya (5 %) spray at 30 and 45 DAS for higher growth and yield in potato.
- आलू में अधिकतम वृद्धि तथा उपज के लिए बुवाई के समय 8 टन/हे की दर से वर्मीकम्पोस्ट + 10% वर्मीवाश + 5% पंचगव्य का बुवाई के 30 एवं 45 दिन के बाद छिड़काव करें ।
46. Vermicompost + Vermiwash + Panchgayva – Onion / वर्मीकम्पोस्ट+ वर्मीवाश + पंचगव्य – प्याज
- Application of Vermicompost (8 t/ha) at sowing + vermiwash (10%) spray at 30 and 45 DAS + Panchagavya (5 %) spray at 30 and 45 DAS for higher growth and yield in onion.
- प्याज में अधिकतम वृद्धि तथा उपज के लिए बुवाई के समय 8 टन/हे की दर से वर्मीकम्पोस्ट + 10% वर्मीवाश + 5% पंचगव्य का बुवाई के 30 एवं 45 दिन के बाद छिड़काव करें ।
47. Vermicompost + Vermiwash + Panchgayva – Garlic / वर्मीकम्पोस्ट+ वर्मीवाश + पंचगव्य – लहसुन
- Application of Vermicompost (8 t/ha) at sowing + vermiwash (10%) spray at 30 and 45 DAS + Panchagavya (5 %) spray at 30 and 45 DAS for higher growth and yield in garlic.
- लहसुन में अधिकतम वृद्धि तथा उपज के लिए बुवाई के समय 8 टन/हे की दर से वर्मीकम्पोस्ट + 10% वर्मीवाश + 5% पंचगव्य का बुवाई के 30 एवं 45 दिन के बाद छिड़काव करें ।
48. Vermicompost + Vermiwash + Panchgayva – Pea / वर्मीकम्पोस्ट+ वर्मीवाश + पंचगव्य – मटर
- Application of Vermicompost (8 t/ha) at sowing + vermiwash (10%) spray at 30 and 45 DAS + Panchagavya (5 %) spray at 30 and 45 DAS for higher growth and yield in pea.
- मटर में अधिकतम वृद्धि तथा उपज के लिए बुवाई के समय 8 टन/हे की दर से वर्मीकम्पोस्ट + 10% वर्मीवाश + 5% पंचगव्य का बुवाई के 30 एवं 45 दिन के बाद छिड़काव करें ।
49. Dashparni – Tomato / दशपर्णी – टमाटर
- Application of dashparni (10%) spray at 40 and 60 DAS for maximum early & late blight disease control and higher growth & yield in tomato.
- टमाटर में अगेती एवं पछेती अंगमारी रोगों के अधिकतम नियंत्रण, उच्चतम वृद्धि और उपजके लिए बुवाई के 40 और 60 दिन के बाद 10% दशपर्णी का छिड़काव करें।
50. Dashparni – Onion/ दशपर्णी – प्याज
- Application of dashparni (10%) spray at 40 and 60 DAS for maximum purple blotch disease control and higher growth & yield in onion.
- प्याज में बेंगनी धब्बा (पर्पल ब्लोच) रोग के अधिकतम नियंत्रण, उच्चतम वृद्धि और उपजके लिए बुवाई के 40 और 60 दिन के बाद 10% दशपर्णी का छिड़काव करें।
51. Higher growth and yield in wheat./ गेहूं में अधिकतम वृद्धि तथा उपज
- Application of 1/3rd RDN through FYM +1/3rd RDN through vermicompost + 1/3rd RDN through neem cake + Jeevamrit @500 lit/ha at 1st and 3rd irrigation + BD 500 (at sowing & 30 DAS) + BD 501 (at 2-4 leaf stage & at flowering stage) for higher growth and yield in wheat.
- गेहूं में अधिकतम वृद्धि तथा उपज के लिए बुवाई के समय अनुसंशित नत्रजन की मात्रा का 1/3 भाग गोबर की खाद से + 1/3 भाग वर्मीकम्पोस्ट से + 1/3 भाग नीम की खली से + जीवामृत 500 लीटर/हे की दर से पहली एवं तीसरी सिंचाई के समय + बुवाई के समय एवं बुवाई के 30 दिन के बाद जैव गतिकी नुस्खा – 500 (बी डी – 500) + 2-4 पत्ती की अवस्था एवं फूल बनने के दौरान जैव गतिकी नुस्खा – 501 (बी डी – 501) प्रयोग करें ।
52. Higher growth and yield in Fenugreek / मेथी में अधिकतम वृद्धि तथा उपज
- Application of 1/3rd RDN through FYM +1/3rd RDN through vermicompost + 1/3rd RDN through neem cake + Jeevamrit @500 lit/ha at 1st and 3rd irrigation + BD 500 (at sowing & 30 DAS) + BD 501 (at 2-4 leaf stage & at flowering stage) for higher growth and yield in fenugreek.
- मेथी में अधिकतम वृद्धि तथा उपज के लिए बुवाई के समय अनुसंशित नत्रजन की मात्रा का 1/3 भाग गोबर की खाद से + 1/3 भाग वर्मीकम्पोस्ट से + 1/3 भाग नीम की खली से + जीवामृत 500 लीटर/हे की दर से पहली एवं तीसरी सिंचाई के समय + बुवाई के समय एवं बुवाई के 30 दिन के बाद जैव गतिकी नुस्खा – 500 (बी डी – 500) + 2-4 पत्ती की अवस्था एवं फूल बनने के दौरान जैव गतिकी नुस्खा – 501 (बी डी – 501) प्रयोग करें ।
53. Higher growth and yield in Fennel / सोंफ में अधिकतम वृद्धि तथा उपज
- Application of 1/3rd RDN through FYM +1/3rd RDN through vermicompost + 1/3rd RDN through neem cake + Jeevamrit @500 lit/ha at 1st and 3rd irrigation + BD 500 (at sowing & 30 DAS) + BD 501 (at 2-4 leaf stage & at flowering stage) for higher growth and yield in fennel.
- सोंफ में अधिकतम वृद्धि तथा उपज के लिए बुवाई के समय अनुसंशित नत्रजन की मात्रा का 1/3 भाग गोबर की खाद से + 1/3 भाग वर्मीकम्पोस्ट से + 1/3 भाग नीम की खली से + जीवामृत 500 लीटर/हे की दर से पहली एवं तीसरी सिंचाई के समय + बुवाई के समय एवं बुवाई के 30 दिन के बाद जैव गतिकी नुस्खा – 500 (बी डी – 500) + 2-4 पत्ती की अवस्था एवं फूल बनने के दौरान जैव गतिकी नुस्खा – 501 (बी डी – 501) प्रयोग करें ।
54. Higher growth and yield in Coriander / धनिये में अधिकतम वृद्धि तथा उपज
- Application of 1/3rd RDN through FYM +1/3rd RDN through vermicompost + 1/3rd RDN through neem cake + Jeevamrit @500 lit/ha at 1st and 3rd irrigation + BD 500 (at sowing & 30 DAS) + BD 501 (at 2-4 leaf stage & at flowering stage) for higher growth and yield in coriander.
- धनिये में अधिकतम वृद्धि तथा उपज के लिए बुवाई के समय अनुसंशित नत्रजन की मात्रा का 1/3 भाग गोबर की खाद से + 1/3 भाग वर्मीकम्पोस्ट से + 1/3 भाग नीम की खली से + जीवामृत 500 लीटर/हे की दर से पहली एवं तीसरी सिंचाई के समय + बुवाई के समय एवं बुवाई के 30 दिन के बाद जैव गतिकी नुस्खा – 500 (बी डी – 500) + 2-4 पत्ती की अवस्था एवं फूल बनने के दौरान जैव गतिकी नुस्खा – 501 (बी डी – 501) प्रयोग करें ।
55. Biochar & Active Silicon – Fenugreek / बायोचार + सिलिकॉन – मेथी
- Application of biochar @ 4 t/ha at the time of sowing and foliar spray of active silicon @ 2.5% at 45 and 90 DAS for higher growth and yield in fenugreek.
- मेथी में अधिकतम वृद्धि तथा उपज के लिए बुवाई के समय 4 टन/हे की दर से बायोचार और बुवाई के 45 एवं 90 दिन के बाद 2.5% सिलिकॉन (डाइएटोमस अर्थद्वारा) का पर्णीय छिड़काव करें ।
56. Herbal bio-pesticide – Cabbage / दशपर्णी + वर्मीवाश + ट्राईकोडर्मा – पत्ता गोभी
- Evaluation of efficacy of herbal bio-pesticide on pest, disease and yield of Cabbage.
- पत्ता गोभी में अल्टरनेरिया ब्लाइट और मृदुल रोमिल आसिता रोगों के अधिकतम नियंत्रण के लिए, अधिकतम वृद्धि तथा उपज के लिए बुवाई के 30, 45 एवं 60 दिन के बाद 10% दशपर्णी + 10% वर्मीवाश + 1% ट्राईकोडर्मा का छिड़काव करें ।
57. Herbal bio-pesticide – Cauliflower / दशपर्णी + वर्मीवाश + ट्राईकोडर्मा – फूलगोभी
- Evaluation of efficacy of herbal bio-pesticide on pest, diseaseand yield of Cauliflower.
- फूलगोभी में मृदुल रोमिल आसिता रोग के अधिकतम नियंत्रण के लिए, अधिकतम वृद्धि तथा उपज के लिए बुवाई के 30, 45 एवं 60 दिन के बाद 10% दशपर्णी + 10% वर्मीवाश + 1% ट्राईकोडर्मा का छिड़काव करें ।
Use of Silica in Agriculture
58. Silicon – Wheat/ सिलिकॉन – गेहूं

- Foliar application of silicon@8 g/litre water through diatomous earth at tillering stage for high seed of wheat under organic farming.
- जैविक खेती में गेहूं की अधिक उपज के लिए 8 ग्राम/लीटर की दर से कल्ले बनने की अवस्था पर पर्णीय छिडकाव करें
59. Silicon – Maize/ सिलिकॉन – मक्का

- Soil application of active silicon @150kg/hain organic maize.
- जैविक मक्का में अधिक उपज के लिए 150 किग्रा/हे सिलिका का मृदा में उपयोग करें
